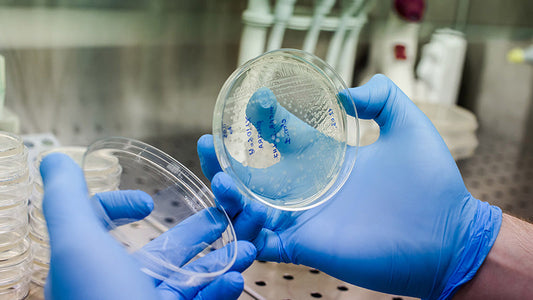
Safe storage & handling of viral vectors

Biopharmaceutical Products
NEWSLETTER SUBSCRIPTION
Get the latest delivered directly to your inbox!
Get the latest delivered directly to your inbox! You can unsubscribe at any time, no hard feelings.